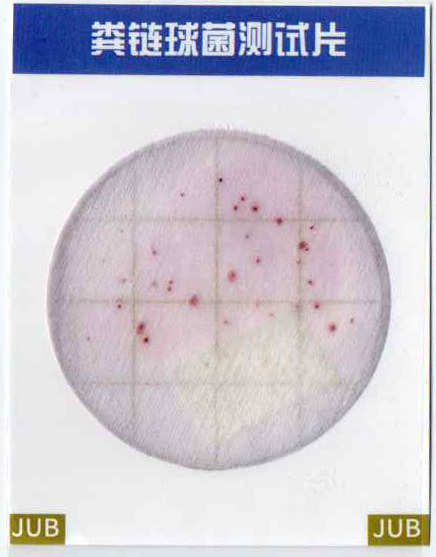

糞鏈球菌測(cè)試片
1 原理及適用范圍糞鏈球菌又叫糞腸球菌,普遍存在于水環(huán)境中,為條件致病菌,它來(lái)源于人和溫血?jiǎng)游锏募S便,偶爾出現(xiàn)于感染的尿道及急性心內(nèi)膜炎,是水體受到糞便污染的重要指標(biāo)菌。它能夠通過(guò)食品對(duì)人類造成感染,糞鏈球菌進(jìn)入食物鏈的主要原因是不衛(wèi)生的加工條件所致的。糞鏈球菌測(cè)試片是一種預(yù)先制備好的一次性培養(yǎng)基產(chǎn)品,含有標(biāo)準(zhǔn)的營(yíng)養(yǎng)培養(yǎng)基,菌落在測(cè)試片上呈紅色帶黃暈斑點(diǎn)。本產(chǎn)品適合于食品中糞鏈球菌群的檢驗(yàn),也適用
產(chǎn)品參數(shù):
詳細(xì)介紹:
1 原理及適用范圍
糞鏈球菌又叫糞腸球菌,普遍存在于水環(huán)境中,為條件致病菌,它來(lái)源于人和溫血?jiǎng)游锏募S便,偶爾出現(xiàn)于感染的尿道及急性心內(nèi)膜炎,是水體受到糞便污染的重要指標(biāo)菌。它能夠通過(guò)食品對(duì)人類造成感染,糞鏈球菌進(jìn)入食物鏈的主要原因是不衛(wèi)生的加工條件所致的。糞鏈球菌測(cè)試片是一種預(yù)先制備好的一次性培養(yǎng)基產(chǎn)品,含有標(biāo)準(zhǔn)的營(yíng)養(yǎng)培養(yǎng)基,菌落在測(cè)試片上呈紅色帶黃暈斑點(diǎn)。本產(chǎn)品適合于食品中糞鏈球菌群的檢驗(yàn),也適用于羽絨制品填充料中糞鏈球菌群的檢驗(yàn)。
執(zhí)行標(biāo)準(zhǔn):SN/T 0475-1995 出口商品中糞鏈球菌群檢驗(yàn)方法
2 操作方法
2.1 樣品處理:
①食品樣:取樣品 25 mL(g)放入含有225 mL滅菌生理鹽水的取樣罐或均質(zhì)杯內(nèi),充分搖勻,制成1:10的樣品勻液。
②羽絨制品填充樣:取樣品 10g放入含有400 mL無(wú)菌水的取樣罐或均質(zhì)杯內(nèi),充分搖勻,制成1:10的樣品勻液。
用1mL滅菌吸管吸取1:10樣品勻液1mL,注入 含有9mL稀釋液的試管內(nèi),振搖后成為1:100的樣品勻液,以此類推,做出1:1000等稀釋度的樣品勻液,每次換一支吸管。
2.2 接種:一般食品選2~3個(gè)稀釋度進(jìn)行檢測(cè),含菌量少的液體樣品(如飲料等)可直接吸取原液進(jìn)行檢測(cè)。取糞鏈球菌測(cè)試片置于平坦實(shí)驗(yàn)臺(tái)面,翻開(kāi)測(cè)試片蓋膜,用無(wú)菌吸管吸取1mL樣品勻液均勻地滴加到紙片上,等待紙片完全吸收液體,慢慢放下蓋膜,每個(gè)稀釋度接種兩片。同時(shí)做一片空白陰性對(duì)照。
2.3 培養(yǎng):放入36 ℃±1 ℃恒溫箱內(nèi)培養(yǎng)16-24h。
3 結(jié)果與報(bào)告
3.1 觀察濾膜上面的菌落特征。在測(cè)試片上生長(zhǎng)的暗紅色或粉紅色菌落即為糞鏈球菌。
3.2 選擇菌落數(shù)在30~300個(gè)的測(cè)試片進(jìn)行計(jì)數(shù),結(jié)果按糞鏈球菌數(shù)/g(mL)為單位報(bào)告。